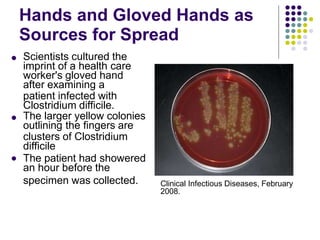
Hands and Gloved Hands as
Sources for Spread
 Scientists cultured the
imprint of a health care
worker's gloved hand
after examining a
patient infected with
Clostridium difficile.
The larger yellow colonies
outlining the fingers are
clusters of Clostridium
difficile
The patient had showered
an hour before the


specimen was collected. Clinical Infectious Diseases, February
2008.

Clostridium difficile is a spore-forming, toxin-producing bacterium that can cause severe diarrhea and life-threatening complications. It is commonly acquired in healthcare settings due to antibiotic use disrupting the normal gut flora. Symptoms range from watery diarrhea to pseudomembranous colitis. Diagnosis involves toxin detection in stool samples. Treatment focuses on antibiotic therapy and infection control measures to limit transmission.